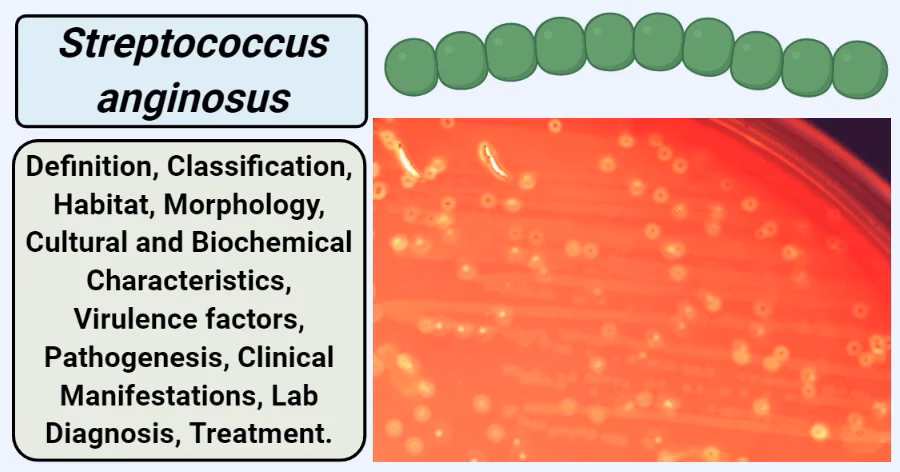
Does Streptococcus anginosus cause infections?

20/06/2019
I den komplekse verden af mikroorganismer, der lever i og på vores kroppe, findes der utallige bakterier, som vi lever i fredelig sameksistens med. Mange af dem er endda gavnlige for os. Men nogle gange kan disse normalt harmløse beboere forvandle sig til alvorlige trusler. Dette er tilfældet med Streptococcus anginosus-gruppen (SAG), en familie af bakterier, der i stigende grad anerkendes som årsag til potentielt livstruende infektioner. Selvom de længe har levet i skyggen af mere kendte streptokokker, viser ny forskning og forbedrede diagnostiske metoder deres sande natur som lumske, opportunistiske patogener.

Hvad er Streptococcus Anginosus Gruppen (SAG)?
Streptococcus anginosus-gruppen, også kendt under det ældre navn Streptococcus milleri-gruppen, er ikke én enkelt bakterie, men en trio af nært beslægtede arter:
- Streptococcus anginosus
- Streptococcus intermedius
- Streptococcus constellatus
Disse bakterier er en del af den normale mikrobielle flora i menneskekroppen, især i mundhulen, svælget, mave-tarmkanalen og de kvindelige kønsorganer. I årtier blev de klassificeret under den brede betegnelse "viridans streptokokker", en gruppe af streptokokker, der generelt blev betragtet som lav-patogene eller harmløse. Denne brede klassificering betød, at de enkelte arter inden for SAG sjældent blev identificeret specifikt i kliniske prøver, og deres rolle i sygdomsprocesser var derfor markant underrapporteret og misforstået.
Fra harmløs beboer til farlig invader: Opportunistiske patogener
Hele nøglen til at forstå SAG's farlighed ligger i begrebet 'opportunistisk patogen'. I modsætning til primære patogener, der kan forårsage sygdom hos raske individer, slår opportunistiske patogener til, når muligheden byder sig. De udnytter en svækkelse i kroppens forsvar til at invadere væv, hvor de normalt ikke hører hjemme, og forårsage infektion.
Faktorer, der kan give SAG denne "mulighed", inkluderer:
- Svækket immunforsvar: Personer med tilstande som HIV/AIDS, kræft, diabetes eller dem, der modtager immunsuppressiv behandling, er i øget risiko.
- Brud på barrierer: Kirurgiske indgreb, traumer, sår eller endda en tandudtrækning kan skabe en indgangsport for bakterierne til at trænge ind i blodbanen eller dybere væv.
- Kroniske sygdomme: Eksisterende sygdomme i organer som lunger, lever eller hjerte kan skabe et miljø, hvor bakterierne kan trives og etablere en infektion.
- Dårlig mundhygiejne: Da mundhulen er et primært reservoir for SAG, kan dårlig tandsundhed føre til en øget mængde af disse bakterier og øge risikoen for, at de spreder sig til andre dele af kroppen.
Kendetegnet for SAG-infektioner: Tendensen til at danne bylder
Et af de mest markante kliniske træk ved infektioner forårsaget af Streptococcus anginosus-gruppen er deres stærke tendens til at danne bylder (abscesser). En byld er en lokaliseret samling af pus, som er en tyk væske bestående af døde hvide blodlegemer, vævsrester og bakterier. Kroppen danner en kapsel omkring bylden for at inddæmme infektionen, men dette gør det også vanskeligt for antibiotika at trænge ind og bekæmpe bakterierne effektivt.
Disse bylder kan opstå næsten overalt i kroppen og føre til alvorlige og livstruende tilstande afhængigt af deres placering:
- Hjerneabscesser: En ekstremt alvorlig tilstand, der kan forårsage neurologiske skader.
- Leverabscesser: Kan føre til leversvigt og systemisk infektion (sepsis).
- Lungeabscesser og empyem: Empyem er en samling af pus i lungehinden (pleurahulen), som kan føre til alvorlige vejrtrækningsproblemer.
- Abscesser i bughulen: Kan opstå efter operationer eller som følge af sygdomme i mave-tarmkanalen.
Udover abscessdannelse kan SAG også forårsage bakteriæmi (bakterier i blodet), endokarditis (infektion i hjertets indre hinder) og andre dybe vævsinfektioner.
Sammenligning af de tre SAG-arter
Selvom de arbejder sammen som en gruppe, er der voksende bevis for, at de tre forskellige arter har en tendens til at forårsage infektioner i forskellige dele af kroppen. Præcis identifikation er derfor vigtig for at forstå sygdomsforløbet.
| Bakterieart | Typiske infektionssteder | Kliniske kendetegn |
|---|---|---|
| S. anginosus | Mave-tarmkanalen, urinvejene, galdevejene | Ofte forbundet med bylder i indre organer som leveren og i bughulen. |
| S. intermedius | Centralnervesystemet (hjerne), hoved-hals-området, luftvejene | Har en særlig stærk tendens til at forårsage hjerneabscesser og infektioner i bihulerne. |
| S. constellatus | Luftvejene (især lunger), brysthulen | Hyppigt identificeret i lungeabscesser, empyem og andre luftvejsinfektioner. |
Vigtigheden af korrekt diagnose og behandling
Den historiske udfordring med SAG har været den manglende præcise diagnose. Traditionelle laboratoriemetoder kunne have svært ved at skelne mellem de forskellige viridans streptokokker. Men med fremkomsten af moderne molekylærbiologiske teknikker, såsom MALDI-TOF MS og 16S rRNA-sekventering, kan mikrobiologiske laboratorier nu identificere de specifikke arter inden for SAG med stor nøjagtighed.
Denne præcision er afgørende. At vide, hvilken specifik art der forårsager infektionen, kan give lægerne vigtige ledetråde om, hvor i kroppen de skal lede efter den primære infektionskilde, især i tilfælde af bylddannelse. For eksempel kan fundet af S. intermedius i blodet få lægen til at mistænke en skjult hjerneabsces.
Behandlingen af SAG-infektioner er ofte en to-delt proces:
- Antibiotika: En målrettet og ofte langvarig behandling med antibiotika er nødvendig for at udrydde bakterierne. Valget af antibiotika afhænger af infektionens placering og bakteriens følsomhed.
- Drænage: På grund af den stærke tendens til bylddannelse er kirurgisk eller billedvejledt drænage af pus næsten altid nødvendig. Uden drænage kan antibiotika have svært ved at nå infektionsstedet i tilstrækkelige koncentrationer, og infektionen vil fortsætte.
Ofte Stillede Spørgsmål (FAQ)
Er Streptococcus anginosus smitsom?
Nej, infektioner med SAG betragtes ikke som smitsomme fra person til person på samme måde som forkølelse eller influenza. Bakterierne er en del af din egen normale kropsflora. Infektionen opstår, når dine egne bakterier flytter sig til et sterilt område i kroppen (f.eks. blodbanen eller et organ) og begynder at formere sig der, typisk på grund af en svækkelse i dit helbred.
Hvem er i særlig risiko for en SAG-infektion?
Personer med underliggende helbredsproblemer er i størst risiko. Dette inkluderer patienter med diabetes, kræft, leversygdomme, samt personer med et kompromitteret immunsystem. Patienter, der for nylig har gennemgået kirurgi, især i mave-tarm-regionen eller mundhulen, har også en forhøjet risiko.
Hvordan kan jeg forebygge en infektion?
Den bedste forebyggelse er at opretholde et godt generelt helbred. En god mundhygiejne, herunder regelmæssige tandlægebesøg, er afgørende for at holde mængden af SAG-bakterier i munden under kontrol. For personer med kroniske sygdomme er det vigtigt at håndtere disse tilstande effektivt i samråd med en læge.
Hvor alvorlige er disse infektioner?
De kan være yderst alvorlige. En ubehandlet byld i et vitalt organ som hjernen eller leveren kan være dødelig. Selv med behandling kan disse infektioner kræve lange hospitalsindlæggelser, aggressive antibiotikakure og kirurgiske indgreb. Tidlig diagnose og behandling er altafgørende for et godt resultat.
Konklusion: En stigende bevidsthed er nødvendig
Streptococcus anginosus-gruppen er et perfekt eksempel på, hvordan vores forståelse af mikrobiologi og infektionssygdomme konstant udvikler sig. Hvad der engang blev betragtet som en ubetydelig del af vores normale flora, anerkendes nu som en vigtig årsag til alvorlige, bylddannende infektioner. Den øgede bevidsthed blandt både klinikere og mikrobiologer, kombineret med bedre diagnostiske værktøjer, er afgørende for at identificere disse skjulte trusler hurtigt og iværksætte den korrekte, livreddende behandling. Mens forskningen fortsætter med at afdække de præcise mekanismer bag deres patogenicitet, er det klart, at disse små bakterier fortjener vores fulde opmærksomhed.
Hvis du vil læse andre artikler, der ligner Streptococcus Anginosus: En skjult trussel, kan du besøge kategorien Sundhed.
